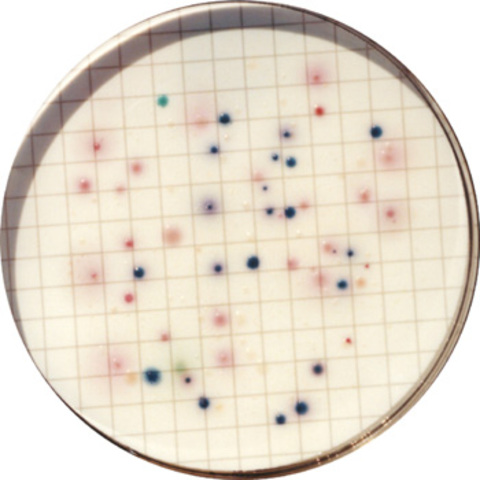
bacteriano

-
fra scatorius, dice que los germenes vivos pasan de un individuo a otro
-
Marcelo Malpighi es el primero en utlixar el microscopio para observar el material biologico
-
Bassi, asocia por primera vez la presencia de un hongo a una enfermedad (malagseno) presente en gusanos de seda
-
Eichstedt, identifico por primera vez a un microorganismo como el agente etiotogico de una enfermedad cutanea humana ( pititriasis versicolor)
-
Devaine, observa por primera vez la presencia en la sangre de animales enfermos de un microorganismos patogeno, BACILLUS ANTRACIS
-
Sem Nelweis, establece la elimologia de la fiebre puerperales.
-
asteur demostró que los microorganismos producían la alteración de alimentos y descubrió la pasterización que consiste en aplicarle a un liquido durante un periodo de 30 minutos una temperatura de 65 grados.
-
se descubrió la teoría infecciosa de las enfermedades, es decir, se demostró que las enfermedades están producidas por microorganismos este descubrimiento también se le debe a Pasteur.
-
lister, introduce la asepsia quirurgica, (pulverizacion fenol) en l las salas donde se intervenia quirurgicamente
-
Kock descubrió que una bacteria causaba una cierta enfermedad e ideo los medios de cultivo. Descubrió el agente causante de la tuberculosis.
-
Pasteur descubrió el fundamento de las vacunas mediante la inyección de bacterias viejas, las cuales, habían perdido la capacidad de producir la enfermedad pero en cambio inducían a la inmunidad frente a los ataques de bacterias jóvenes.
-
Carlos Finlay observa que la fiebre amarilla es transmitida por mosquitos.
-
Louis Pasteur puso a punto una vacuna contra la rabia.
-
Beijerinck aísla bacterias fijadoras de nitrógeno de los nódulos presentes en las raíces de leguminosas.
-
Serguéi Winogradski estudia las bacterias del azufre y las bacterias nitrificantes.
-
Dimitri Ivanovski demuestra que el mosaico del tabaco es producido por un virus.
-
se descubrió el Salvansaw efectivo contra la sífilis.
-
se descubre la penicilina, este descubrimiento fue casual
-
se descubren las sulfamidas
-
Florey, Chain y Fleming consiguen sintetizar la penicilina en forma cristalina.
-
McLead, McCartry y Awery descubren que el ADN es el material genético de las bacterias.
-
Watson y Crickdescubren la estructura del ADN y como se replica.
-
se descubre el interferol que puede inhibir la replicación de algunos virus el interferol esta en nuestro propio organismo
-
Robert W. Holley aísla los tRNA, moléculas que incorporan los aminoácidos activados en las proteínas.
-
Whitaker añadió 2 reinos mas y los clasifico en reino plantae, animalia, protoctista, algae y monera.
-
Bruce Ames pone a punto un test bacteriano para detectar mutágenos y carcinógenos:
-
Frederick Sanger desarrolla el método de los dideoxinucleótidos para la secuenciación del DNA
-
Woese secuencio el ARN ribosómico que participa en la síntesis de las proteínas y concluyó en que solo existían 3 reinos que son Archaea, bacteria y eukaya. El Archaea formado por raras bacterias como las metanógenas que producen CH4 olas acidotermofilas y sulfurosas. En los eukaya incluyo algas, animales, protozoos, hongos, debido a que tenemos similar molécula de ARN ribosómico.
-
Priones, encefalopatia, espongifore bovina y enfermedad de creutzfeldt- jako
Prusiner describio los Priones. -
utilizó la Taq polimerasa para llevar a cabo la PCR (reacción en cadena de la polimerasa)
-
Barry Marshall y Robin Warren demuestran el papel de Helicobacter pylori en la úlcera de estómago
-
Robert Gallo y Luc Montagnier llevan a cabo el aislamiento e identificación del virus del sida.
-
Las bacterias pueden tener cromosomas lineales
-
se secuencia el genoma de la bacteria Haemophilus influenzae.
-
se secuencia el genoma de la bacteria Escherichia coli.
-
se descubre la bacteria gigante Thiomargarita namibiensis.3
-
se secuencia el genoma del Saccharopolyspora erythraea, el microorganismo productor del antibiótico eritromicina.
-
en México aparece un brote de gripe porcina, posteriormente llamada gripe A H1N1.
-
Prusiner descubre los priones, agentes causantes de la encefalopatía espongiforme bovina y de la enfermedad de Creutzfeldt-Jakob.
A list shows items. A timeline shows sequence.
Use Timetoast to make dates, milestones, and turning points easier to understand in a clear visual format. Timetoast is a timeline maker for work, school, research, and stories.